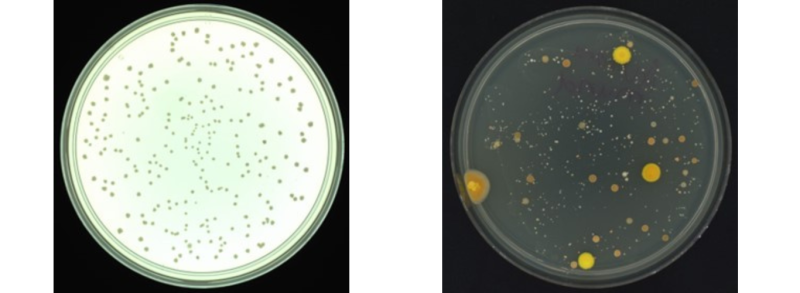

Synbiosis is a division of Synoptics that deal in the automated colony counter market and have a variety of devices that can aid the user in various ways, including measuring inhibition zones and spiral plates. The primary use of our products is for quick and easy counting of colony-forming units, also known as CFUs.
What is a “CFU”?
What is a “colony forming unit”, I hear you ask? Well, we can begin with a bacterial culture that has been collected. Next, a small amount of the culture, usually around 1ml, is added to the petri-dish, followed by around 15ml of molten agar. A lid is then placed on the petri-dish before being swirled gently so that the culture and agar are mixed thoroughly. This method is known as the pour plate method.
Once the plate has solidified, they are inverted and incubated at a user-specified temperature, usually around 37⁰C, for 24 to 48 hours. Of course, a range of other techniques and methods can be used for culturing bacteria, but this gives you an idea of one of the more common methods works. Regardless of your method, you can see what colonies have formed on the plate after the elapsed time.
Colonies can be a variety of microbial organisms, including bacteria, fungi, and moulds. Each colony will start as a single bacterium. By leaving them to incubate in ideal conditions for at least 24 hours, this single bacterium can divide and divide and divide, giving rise to a large enough number of the organism to become visible to the human eye in the form of a colony. Therefore, the colony itself is a clonal population that has descended from one viable organism, and this original organism that started the colony is known as one colony-forming unit or CFU.
It is important to remember that only viable colonies can grow on these plates. Any dead or non-dividing bacteria will not be able to form colonies. Therefore, only viable colonies will be counted in the final count.
How can we help you with this?
This is where the Synbiosis product range comes in. Traditionally, viable colonies will be manually counted on each plate by someone sitting and marking the lid or base of the petri dish with a marker pen. But, with some plates with hundreds or even thousands of CFUs, we know you can use a helping hand!
Synbiosis automated colony counters allow a user to place the plate inside the machine, and our bespoke imaging software will detect the number of CFUs on the plate. No matter what shape, size, colour, or morphology of the CFUs, our automated colony counters can count the viable colonies with a very high degree of accuracy in just a few seconds. This speed, coupled with a review function, allows the user to look at the image and quickly add or remove colonies, meaning plates that would take several minutes to be counted manually are now measured in seconds, saving you time and allowing your team to focus on the results.
But I want to know more than just the CFU count!
You’re in luck, then! While the CFU count itself can be useful, plenty of scientists, technicians, and researchers need more information than this.
The sample begins as a diluted culture at the start of the process, meaning only a tiny portion is used before mixing with the agar in the pour plate. A more common way to report the number of viable colonies in a sample is by expressing the result in the format of CFU per ml. This result will work the final count on the plate backwards, factoring in any dilutions that have been done and the amount used to spread on the plate, to give a value of how many viable colonies would be expected in the total sample.
A simple formula used for calculating the CFU/mL is as follows:
CFU/mL = (number of colonies x dilution factor) / volume of culture on a plate
For example, a starting culture contains 10mL of the sample. 1mL of this sample is diluted with 9mL of diluent to create a 1 in 10 dilution. From this dilution, 1mL is spread onto the plate. After incubation and counting, the colony counter finds that 38 viable colonies have grown on the plate. By putting these values into the calculation, we can see that:
CFU/mL = (38*10) / 1
CFU/mL = 380

While this is an expected count that many people will want, a variety of data can be produced on our reports with the ProtoCOL and its fellow colony counters. These fields include colony name, dilution factors, mean count per ml, count per frame, plate area, and many more customisable options, including a statistics package to allow you to crunch all your data in more ways than you could imagine.
We all know that counting the CFUs on plates manually can be incredibly tedious, and we’d love to be cracking on with more important things. However, when counting your CFUs as efficiently as possible, there’s nowhere better to look than here at Synbiosis. If you want to learn more about our products and see how they could benefit your lab, then feel free to get in contact with me or anyone else in the Synbiosis team or check out our products page to find the right device for you!

